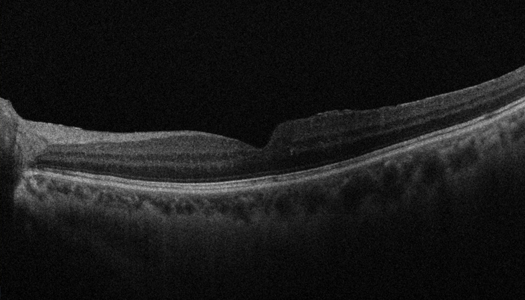
망막 정맥이 폐쇄되어 유리체강내 주사 치료를 받고 호전된 환자

언제나 건강한 눈으로 사랑하는 것을
바라볼 수 있도록 함께 하겠습니다.

‘눈에 생기는 중풍’ 불리는 망막 혈관 질환은 망막동맥 폐쇄, 망막정맥 폐쇄, 안허혈증후군, 고혈압망막병증 등 다양한 원인과 형태로 발생합니다.
그중에서 혈액순환 문제로 인해 망막 혈관이 막히고 산소공급이 저하됨에 따라 발생한 망막 손상이 발생해 혈관에 출혈이 생기는 질병을 망막 혈관 폐쇄증이라고 합니다.


정상시야

망막혈관폐쇄 시야

망막동맥 폐쇄
혈관이 폐쇄된 위치에 따라 망막중심동맥 폐쇄, 망막분지 동맥폐쇄 등으로 나눌 수 있습니다. 발생 원인이 불분명한 경우가 많으나 색전이나 혈전 등의 요인이 유발요인으로 작용하는 경우도 있습니다.
시력 예후가 좋지 않으며 전신질환에 의해서 발생하는 경우가 많습니다.

망막정맥 폐쇄
혈관이 폐쇄된 위치에 따라 망막중심정맥 폐쇄, 망막분지 정맥폐쇄 등으로 나눌 수 있습니다. 고혈압, 당뇨, 고지혈증 등으로 인해 정맥 폐쇄가 유발될 수 있습니다. 안과적 응급질환으로 구별되진 않으며 치료 예후도 좋은 편이지만, 질환 특성상 정맥이 서서히 좁아지기 때문에 빠른 치료가 이루어지지 않을 경우 시력저하가 동반될 수 있습니다. 따라서 전신질환에 대한 검사를 시행하여 이에 대한 치료가 이루어지도록 해야 합니다.
형광안저혈관조영, 빛간섭단층촬영, 빛간섭 단층 혈관조영술 등을 통해 다양한 망막혈관질환을 진단하게 됩니다.
원인 질환에 따라 크게 약물치료, 안구내주입술, 레이저치료, 수술 등으로 치료 합니다. 심각한 시력 저하뿐만 아니라 합병증 또한 초래할 수 있으므로 빠른 치료가 필요합니다.

망막 정맥이 폐쇄된 환자
치료 전
망막 정맥이 폐쇄되어 유리체강내 주사 치료를 받고 호전된 환자
치료 후
권진우 성모안과는 전문성을 갖춘 의료진이 당일 치료 시작을
원칙으로 환우분들의 치료를 시작합니다.